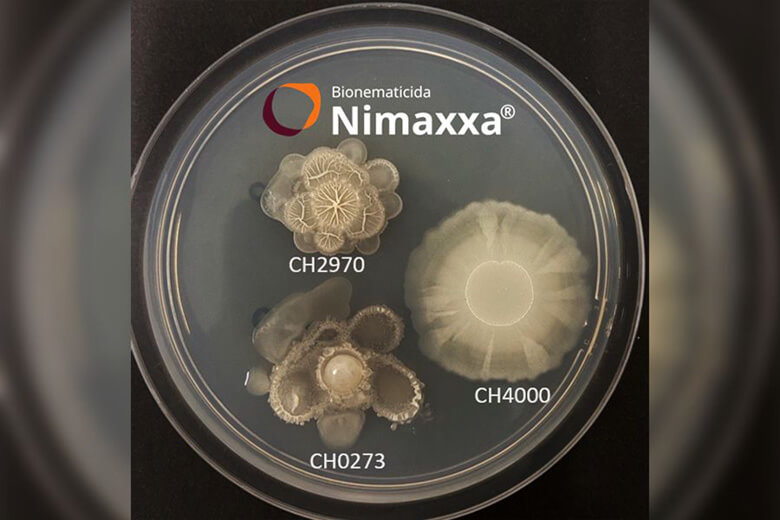

- Novo registro, de bioestimulante, foi aprovado pelo Ministério da Agricultura
- Produto já possuía registro como nematicida biológico
- Formulação inovadora através do melhoramento de Cepas bacterianas
A UPL Ltd. (NSE: UPL, BSE: 512070, LSE: UPLL), fornecedora global de soluções agrícolas sustentáveis, obteve o registro do primeiro bionematicida bioestimulante para agricultura no Brasil. Nimaxxa, lançado recentemente e que já era comercializado como nematicida biológico, passou por testes e validações científicas que comprovaram sua eficácia também para estimulação das plantas resultando em aumento de produtividade dos cultivos. O registro de bioestimulante já foi publicado pelo Ministério da Agricultura e Pecuária (Mapa).
O produto – que integra o portfólio da Natural Plant Protection (NPP), unidade de negócios da UPL que tem foco em biossoluções – é composto por três Cepas de bactérias do gênero Bacillus: B. paralicheniformis, B. paralicheniformis e B. subtilis. Essas três cepas, que foram cuidadosamente selecionadas, são exclusivas da UPL e atuam de forma complementar para garantir a proteção e a estimulação do crescimento das plantas.
Rogério Castro, CEO da UPL Brasil, afirma: "Esta conquista faz parte de nossa estratégia contínua em desenvolver soluções com foco nos agricultores, cuja vocação é produzir para alimentar o planeta. Este marco não só demonstra o potencial e robustez de Nimaxxa, como fortalece a meta global da UPL de ser referência em sustentabilidade, tecnologia e inovação".
Bruno Carloto, gerente de tratamento de sementes e saúde do solo da UPL Brasil, complementa: "Nimaxxa é prova concreta de um conceito exclusivo da UPL, o OpenAg, que nos transforma em uma rede de inovação agrícola colaborativa e aberta. Essa biossolução representa um grande avanço tecnológico, possuindo efeitos de estimulação que realmente resultam em maior produtividade de maneira sustentável. O novo registro reflete nosso consistente investimento e orgulhoso pioneirismo nesse segmento".
Segundo Carloto, os três agentes biológicos presentes no Nimaxxa, uma vez aplicados, colonizam rapidamente as raízes, formando um biofilme (uma barreira biológica) que perdura durante todo o ciclo da cultura, protegendo a planta contra os principais nematoides – como o nematoide do cisto, das galhas e das lesões – e oferecendo um efeito bioestimulante, conforme atestado pelo novo registro obtido junto ao Mapa após o rígido processo regulatório que é característico no setor.
Outra vantagem de Nimaxxa é que o bionematicida bioestimulante tem validade de 2 anos sem refrigeração. Isso representa um grande avanço tecnológico em termos de biológicos, segundo Carloto. Ele possui ainda alta compatibilidade com insumos químicos, podendo ser misturado com todos os tratamentos de sementes do mercado. Já as sementes tratadas com Nimaxxa – produto que é resultado de uma parceria entre UPL e Novonesis, empresa global especializada em biossoluções – podem ser armazenadas por até 6 meses sem perda de viabilidade.
Sobre a UPL
A UPL Ltd. (NSE: UPL & BSE: 512070, LSE: UPLL) é uma fornecedora global de produtos e soluções agrícolas sustentáveis, com receita anual superior a US$ 6 bilhões. Somos uma empresa com propósito. Por meio do OpenAg®, a UPL está focada em acelerar o progresso do sistema alimentar. Estamos construindo uma rede que está reimaginando a sustentabilidade, redefinindo a maneira como uma indústria inteira pensa e trabalha – aberta a novas ideias, inovação e novas respostas enquanto nos esforçamos para cumprir nossa missão de tornar cada produto alimentício mais sustentável. Como uma das maiores empresas de soluções agrícolas do mundo, nosso robusto portfólio consiste em soluções biológicas e tradicionais de proteção de cultivos com mais de 14.000 registros. Estamos presentes em mais de 130 países, representados por mais de 10.000 colaboradores em todo o mundo. Para obter mais informações sobre nosso portfólio integrado de soluções em toda a cadeia de valor alimentar, incluindo sementes, pós-colheita, bem como serviços físicos e digitais, visite upl-ltd.com e siga-nos no LinkedIn, Instagram e Facebook.
Sobre a NPP
A Natural Plant Protection (NPP) oferece aos agricultores um portfólio abrangente de biossoluções – insumos agrícolas naturalmente derivados. Abrangendo a resiliência das culturas; a proteção contra pragas, doenças e desafios ambientais; melhorando a nutrição; e dando suporte à saúde do solo, as biossoluções da NPP melhoram a produtividade e rentabilidade das fazendas sem comprometer o meio ambiente. Com nove plantas de produção, seis laboratórios de P&D e sete estações experimentais ao redor do mundo, e uma rede de distribuição presente em mais de 130 países, a NPP é uma líder global em biossoluções sustentáveis. Unidade comercial da UPL e parte da Rede OpenAg da UPL, a NPP reimagina a sustentabilidade com a utilização de micropoderes para criar macroimpactos e permitir uma agricultura forte para resistir às adversidades climáticas.